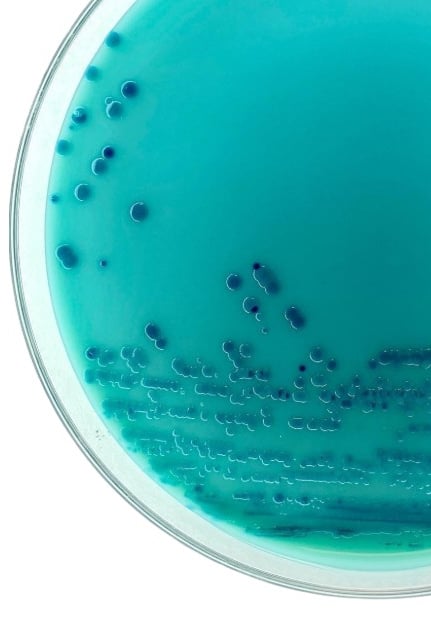

Science- Led Cleaning for
High-Use Environments
Infection prevention, surface integrity,
and chemical methodology
applied with clinical discipline and
operational control.


We deliver controlled environmental care for facilities where risk, exposure,
and outcomes must be managed—not guessed.
Our protocols are informed by applied microbiology, surface chemistry,
and epidemiology fundamentals.
These are executed using professional-grade commercial agents
aligned with established industry leaders, including Ecolab and Spartan Chemicals.
Each environment is assessed based on microbial behavior, material compatibility,
traffic patterns, and operational constraints.
Cleaning and disinfection processes are then selected to achieve
consistent, measurable risk reduction while preserving long-term surface integrity.
Our programs are structured around infection prevention and environmental control principles,
supported by monitoring and documented verification.
Instrumentation is applied to assess conditions and guide decisions
—ensuring consistent, predictable outcomes without unnecessary intervention.
This approach supports facilities that require reliability, documentation, discretion,
and structured systems aligned with infection prevention principles,
professional-grade chemistry, and outcome-based workflow tracking.
This is not cosmetic cleaning, nor labor hours deployed to regulate complex environments. Learn more in Veppa Method.
Applicable Environments
Medical and outpatient facilities
Universities and research environments
Museums and cultural institutions
High-traffic commercial and professional spaces
Commercial Care
Science-driven tailored for your workspace.

Infection Prevention Through Environmental Control
Veppa Services implements infection prevention
programs shaped by experience in
regulated and high-consequence environments.
Each system is structured around microbial
behavior, surface interaction, and chemical
efficacy—supporting consistent risk reduction
and long-term environmental control.
Surface Disinfection Expertise under chemical methodologies
Disinfection agents and processes are
selected based on chemical composition,
reactivity, material compatibility, and
long-term impact.
Advanced disinfection is applied
where appropriate, aligned with modern
infection prevention practices and
the physical realities of the surfaces
being treated.
Microbiology-Driven Cleaning
Cleaning guided by an understanding of
microbial behavior across surfaces,
materials, and environments.
Protocols are developed through applied microbiology, chemical science, and
real-world operating conditions
—focused on prevention, accuracy,
and measurable outcomes, not assumptions.
If we are entrusted with an environment, we are obligated to understand it.
CLEANING THROUGH SCIENCE








LED BY EXPERIENCE
Get in Touch
Reach out to schedule a tailored commercial walkthrough
and environmental assessment.


